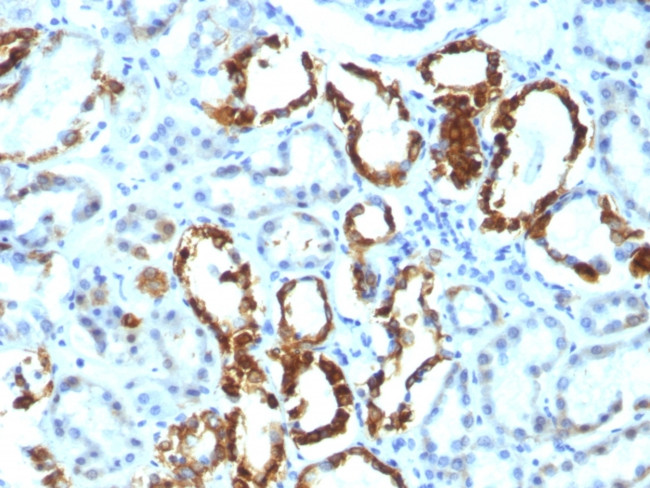
Milk Fat Globule (Breast Epithelial Marker) Antibody in Immunohistochemistry (Paraffin) (IHC (P))

Search
NeoBiotechnologies
Milk Fat Globule (Breast Epithelial Marker) Monoclonal Antibody (EDM45)
{{$productOrderCtrl.translations['antibody.pdp.commerceCard.promotion.promotions']}}
{{$productOrderCtrl.translations['antibody.pdp.commerceCard.promotion.viewpromo']}}
{{$productOrderCtrl.translations['antibody.pdp.commerceCard.promotion.promocode']}}: {{promo.promoCode}} {{promo.promoTitle}} {{promo.promoDescription}}. {{$productOrderCtrl.translations['antibody.pdp.commerceCard.promotion.learnmore']}}
产品信息
4240-MSM2-P1ABX
种属反应
宿主/亚型
分类
类型
克隆号
抗原
偶联物
形式
浓度
规格
纯化类型
保存液
内含物
保存条件
运输条件
靶标信息
This gene encodes a preproprotein that is proteolytically processed to form multiple protein products. The major encoded protein product, lactadherin, is a membrane glycoprotein that promotes phagocytosis of apoptotic cells. This protein has also been implicated in wound healing, autoimmune disease, and cancer. Lactadherin can be further processed to form a smaller cleavage product, medin, which comprises the major protein component of aortic medial amyloid (AMA). Alternative splicing results in multiple transcript variants.
仅用于科研。不用于诊断过程。未经明确授权不得转售。
篇参考文献 (0)
生物信息学
蛋白别名: Breast epithelial antigen BA46; HMFG; Lactadherin; medin; MFG-E8; MFGM; milk fat globule membrane; milk fat globule membrane protein; milk fat globule protein; Milk fat globule-EGF factor 8; milk fat globule-EGF factor 8 protein; O-acetyl disialoganglioside synthase; SED1; sperm associated antigen 10; sperm surface protein hP47; unnamed protein product
基因别名: BA46; EDIL1; HMFG; hP47; HsT19888; MFG-E8; MFGE8; MFGM; OAcGD3S; SED1; SPAG10
UniProt ID: (Human) Q08431
Entrez Gene ID: (Human) 4240